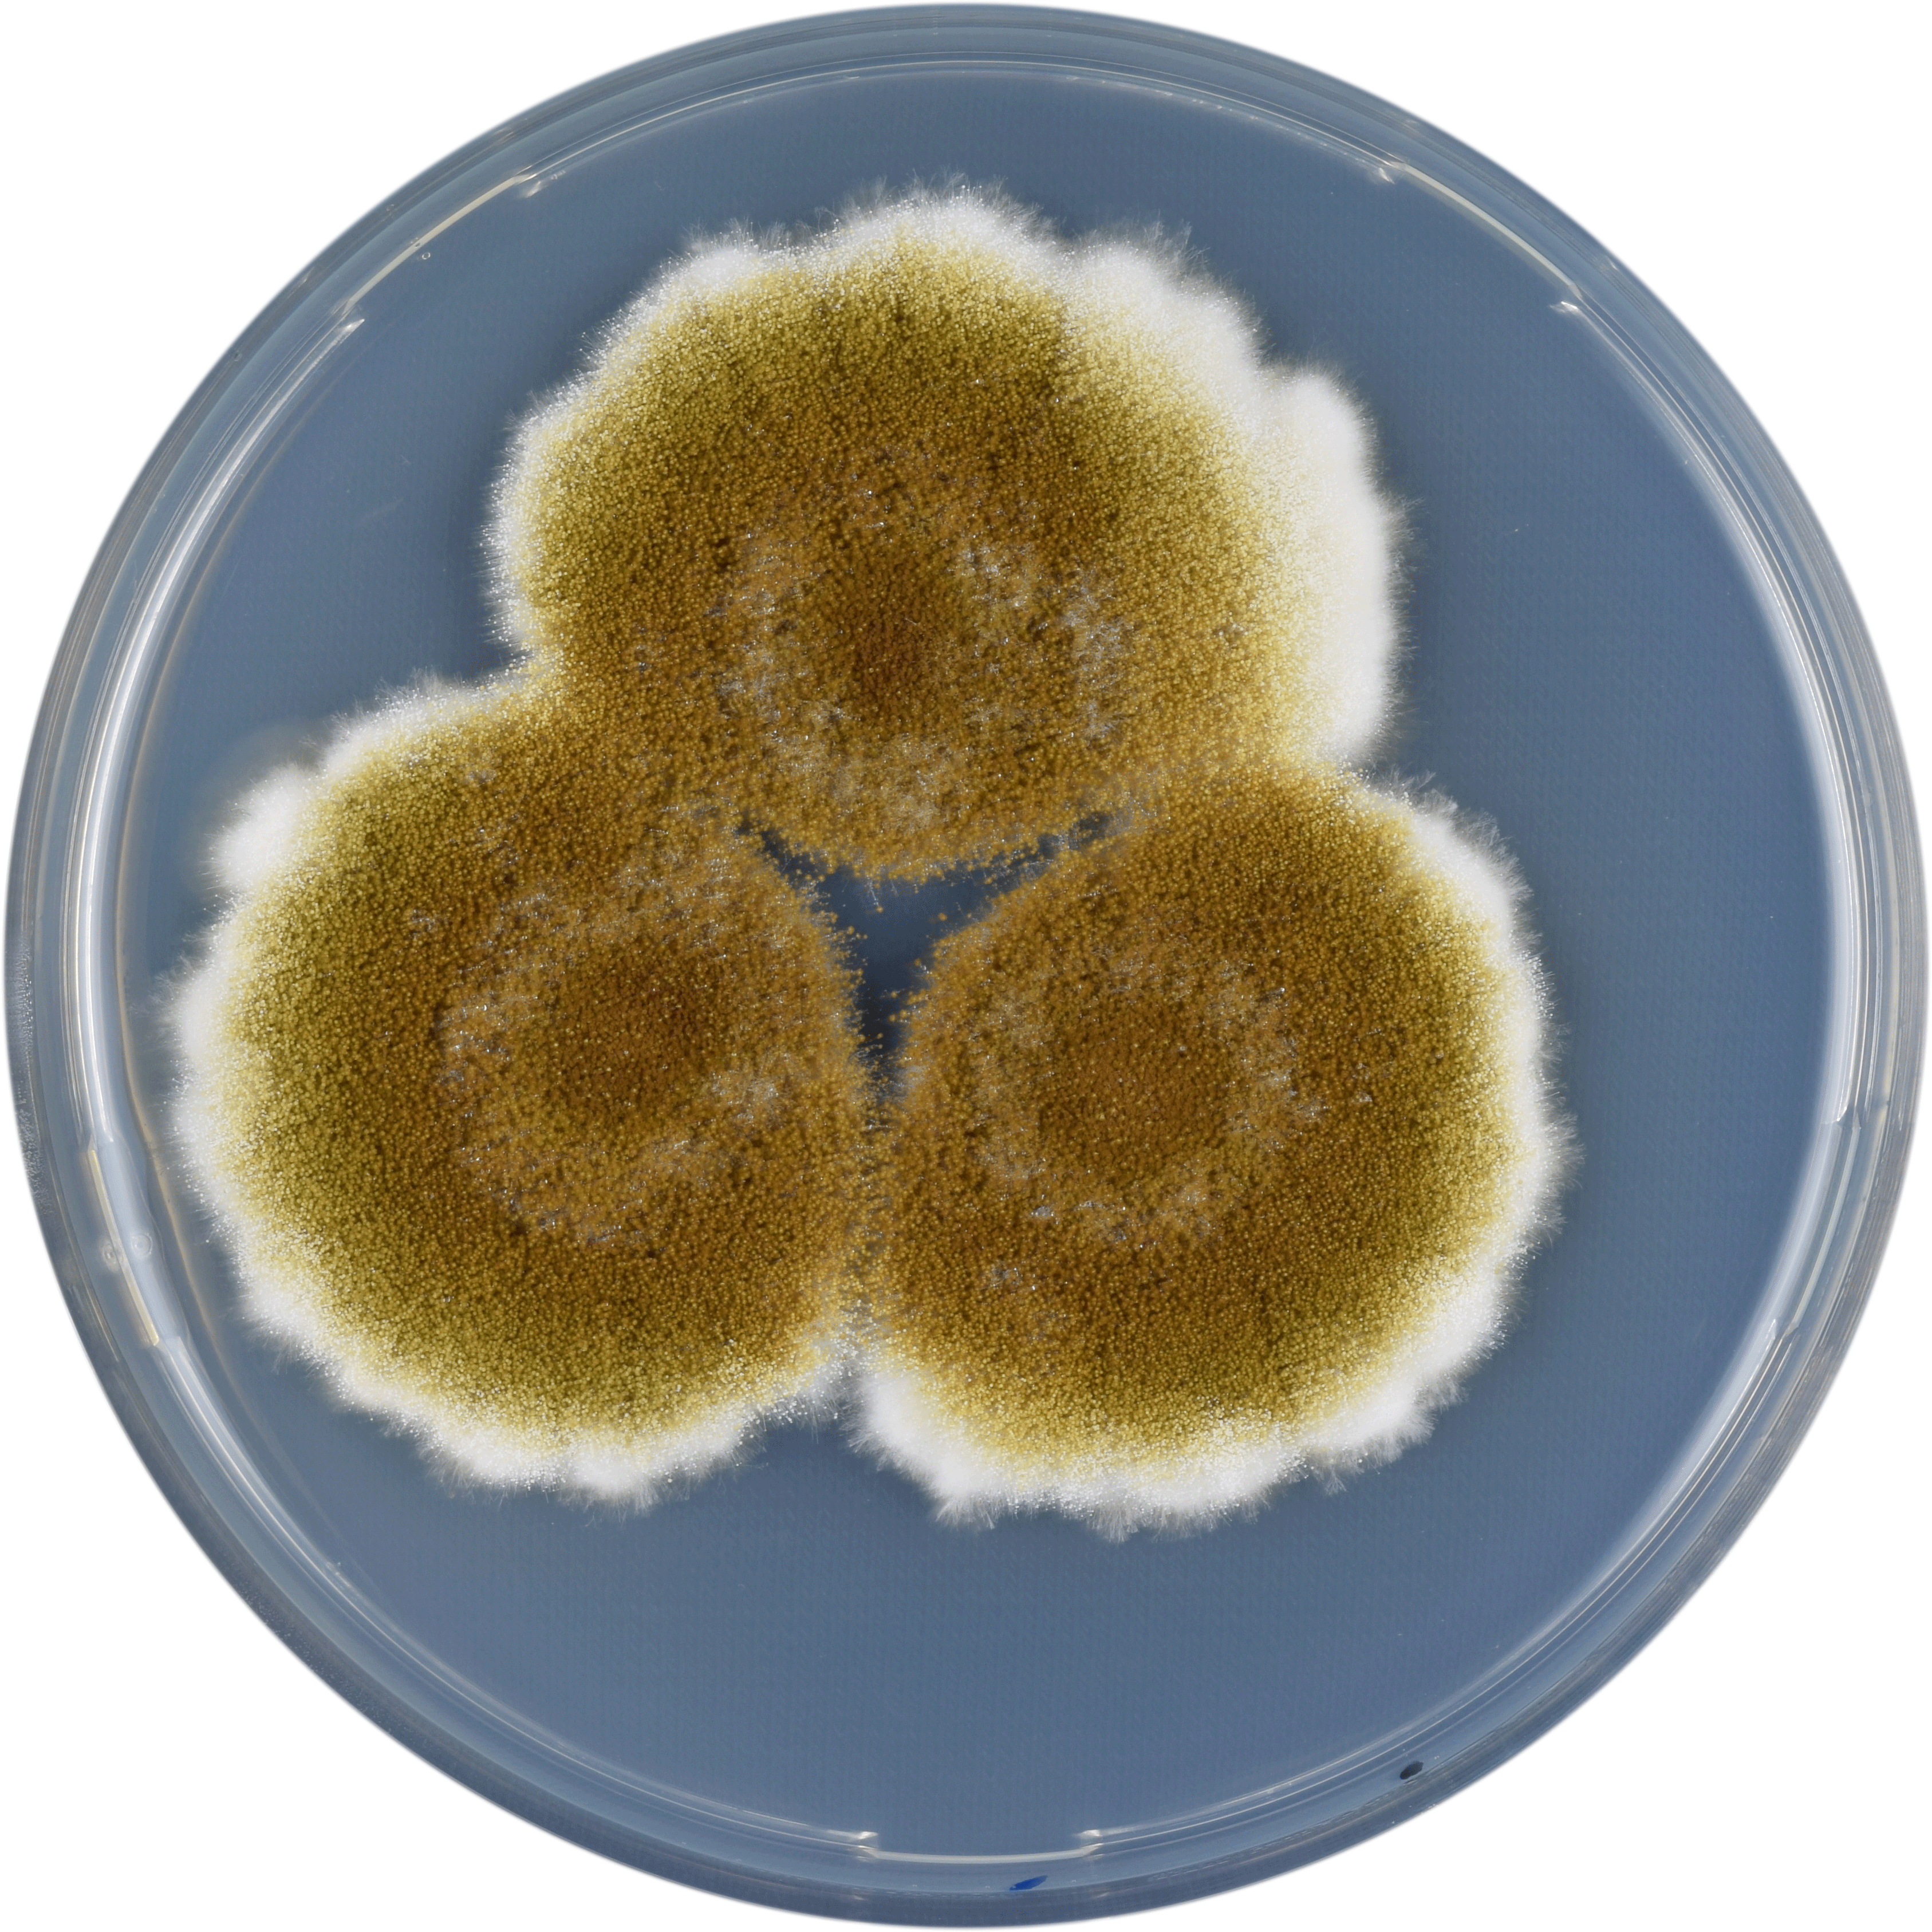
Aspergillus Tamarii Cya - Aspergillus Tamarii (3374x3374), Png Download

Aspergillus Tamarii Cya - Aspergillus Tamarii
Share
: Aspergillus Tamarii Cya - Aspergillus Tamarii
Format: PNG
Dimensions: 3374x3374 px
Size: 4860 KB
Downloads: 2
Report image
Are you looking for high quality transparent PNG images? PNGkit provides Aspergillus Tamarii Cya - Aspergillus Tamarii which is a free photo resource that can be downloaded without a limit. The PNG image is transparent background, and its resolution is 3374x3374. You can download the image and further process it based on your needs. Aspergillus Tamarii Cya - Aspergillus Tamarii is about null. It has thousands of categories, you just need to search to find the pictures you want.
Short Link (Direct Image Link)
Code for Inserting an Image for Your Blog or Website